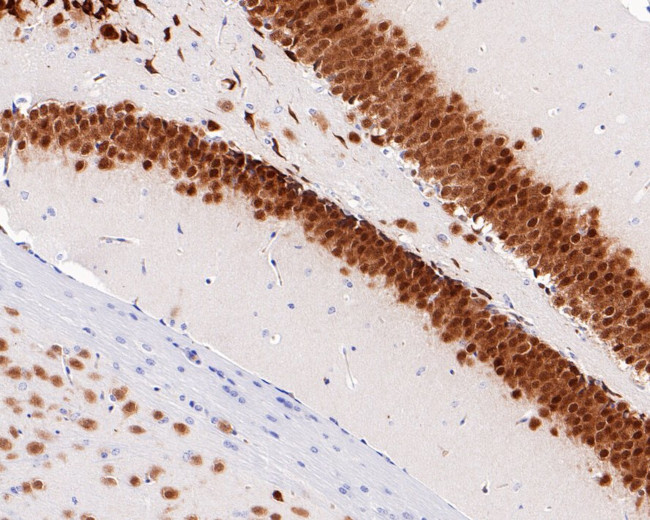
NeuN Antibody in Immunohistochemistry (Paraffin) (IHC (P))

Search
Invitrogen
NeuN Recombinant Mouse Monoclonal Antibody (PD01-45)
{{$productOrderCtrl.translations['antibody.pdp.commerceCard.promotion.promotions']}}
{{$productOrderCtrl.translations['antibody.pdp.commerceCard.promotion.viewpromo']}}
{{$productOrderCtrl.translations['antibody.pdp.commerceCard.promotion.promocode']}}: {{promo.promoCode}} {{promo.promoTitle}} {{promo.promoDescription}}. {{$productOrderCtrl.translations['antibody.pdp.commerceCard.promotion.learnmore']}}
图: 1 / 10
NeuN Antibody (MA5-50648) in IHC (P)










Please note: We are reviewing Western blot images included in the antibody testing data in our catalog, including those provided by third parties. Unless expressly labeled or annotated as “raw-unedited”, Western blot images included in the antibody testing data in our catalog may have been edited, optimized or otherwise adjusted for presentation.
产品信息
MA5-50648
种属反应
已发表种属
宿主/亚型
Expression System
分类
类型
克隆号
抗原
偶联物
形式
浓度
规格
纯化类型
保存液
内含物
保存条件
运输条件
RRID
产品详细信息
Positive control: SH-SY5Y cell lysate, SHG44 cell lysate, Human brain tissue, mouse hippocampus tissue, mouse brain tissue, mouse cerebellum tissue, rat hippocampus tissue, rat brain tissue, rat cerebellum tissue, mouse cerebellum tissue lysates, mouse cerebral cortex tissue.
Predicted band size: 34 kDa
Subcellular Location: Cytoplasm, Nucleus.
靶标信息
Fox-3, also known as NEUN, HRNBP3, RBFOX3 (RNA binding protein, fox-1) or Fox-1 homolog C, is a 350 amino acid protein that contains one RRM (RNA recognition motif) domain. Localized to both the nucleus and cytoplasm, Fox-3 is suggested to regulate alternative splicing events. Fox-3 is encoded by a gene located on human chromosome 17, which is comprised over 2.5% of the human genome and encodes over 1,200 genes. Two key tumor suppressor genes are associated with chromosome 17, namely, p53 and BRCA1. Tumor suppressor p53 is necessary for maintenance of cellular genetic integrity by moderating cell fate through DNA repair versus cell death. Malfunction or loss of p53 expression is associated with malignant cell growth and LiFraumeni syndrome. Like p53, BRCA1 is directly involved in DNA repair, though specifically it is recognized as a genetic determinant of early onset breast cancer and predisposition to cancers of the ovary, colon, prostate gland and fallopian tubes.
仅用于科研。不用于诊断过程。未经明确授权不得转售。
生物信息学
蛋白别名: FLJ56884; FLJ58356; fox 1 homolog (C. elegans) 3; Fox-1 homolog C; Fox-3; fox1 homolog C; FOX3NeuN; hexaribonucleotide binding protein 3; hexaribonucleotide binding protein 3 (HRNBP3); Hexaribonucleotide-binding protein 3; NeuN antigen; neuronal nuclear antigen A60; neuronal nuclei; Neuronal nuclei antigen; RFOX3; RNA binding protein; RNA binding protein fox-1 homolog 3; RNA binding protein, fox-1 homolog 3
基因别名: D11Bwg0517e; Fox-3; Hrnbp3; NeuN; Neuna60; RBFOX3; RGD1560070
UniProt ID: (Mouse) Q8BIF2
Entrez Gene ID: (Rat) 287847, (Mouse) 52897